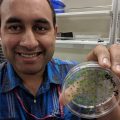

Non-invasive technology to aid global food security
- Like
- Digg
- Del
- Tumblr
- VKontakte
- Buffer
- Love This
- Odnoklassniki
- Meneame
- Blogger
- Amazon
- Yahoo Mail
- Gmail
- AOL
- Newsvine
- HackerNews
- Evernote
- MySpace
- Mail.ru
- Viadeo
- Line
- Comments
- Yummly
- SMS
- Viber
- Telegram
- Subscribe
- Skype
- Facebook Messenger
- Kakao
- LiveJournal
- Yammer
- Edgar
- Fintel
- Mix
- Instapaper
- Copy Link
Posted: 24 August 2022 | Dr Gajendra Pratap Singh, Dr Mervin Chun-Yi Ang | No comments yet
Colleagues from SMART DiSTAP in Singapore share how their non-invasive plant health monitoring technology can be used to improve crop yields to help combat global food insecurity.


According to the World Economic Forum, it is estimated that by 2050, with the global population expected to reach approximately 10 billion, the demand for food will be 60 percent higher than today, putting our food supplies under greater stress.
Climate change, pandemics, urbanisation, soil degradation and wars all contribute to reducing the availability of arable land. In addition, water shortages, pollution, political turmoil and poverty give greater impetus to the alarming issue of world hunger. Innovative approaches that are disruptive and promote sustainable agricultural practices are urgently needed to increase crop yield and help meet the rising demand for food while adapting to changing climates.
Established in 2007, the Singapore-MIT Alliance for Research and Technology (SMART), the Massachusetts Institute of Technology’s (MIT) research enterprise in Singapore, in partnership with the National Research Foundation of Singapore (NRF), is MIT’s first, and to-date only, research centre outside the US. It is also MIT’s largest international research programme. The Disruptive and Sustainable Technologies for Agricultural Precision (DiSTAP), one of SMART’s interdisciplinary research groups (IRGs), is a collaboration between SMART and the Temasek Life Sciences Laboratory (TLL). It seeks to address pressing issues in food production, both in Singapore and globally. The DiSTAP programme is developing a suite of novel technologies that are fundamentally changing how plant biosynthetic pathways are discovered, monitored, engineered and ultimately translated to meet the global demand for food and nutrients.
This article briefly describes the development of nanosensor and Raman technologies at DiSTAP for real-time monitoring of plant health, and their translation from the laboratory to the farm. These sensor technologies aim to enable the farmer to maximise yield and improve crop modularity and quality.
Development and impact of engineered plant nanosensors
Plant health monitoring is a promising strategy that could be used for the optimisation of crop growth practices in high-tech urban farms to enhance yield. Plants are known to transmit various internal biotic and abiotic signals under stress. Detection of these stress-induced signalling molecules in crops can provide farmers with a wealth of information about their growth, development and health.
Transgenic plants containing genetically encoded biosensors are ideal for studying the dynamics of different signalling molecules within model plant species, such as thale cress (Arabidopsis thaliana), that are amenable to genetic modification in a laboratory setting.1
However, it is challenging to extend these genetically encoded biosensors to non-model plants that are agriculturally relevant without established genetic transformation techniques. Hence, the measurement of plant metabolite levels in crops still typically relies on traditional mass spectrometry-based techniques.2 However, these methods greatly limit the potential of plant health monitoring in influencing farm management decisions on a day-to-day basis, as they are destructive and highly labour intensive.
In recent years, the emergence of non-destructive sensors facilitated more efficient plant health monitoring by tapping into the plants’ physiological events in real time without the need to extract or cut up leaf samples3. Optical nanosensors based on near-infrared fluorescent carbon-based nanomaterials, such as single-walled carbon nanotubes, constitute an attractive strategy for the detection of plant hormones and signalling molecules in living plants.4,5 These biocompatible nanosensors, smaller than the width of a hair, can be infused into the plant tissues and cells to understand complex internal signalling pathways of the plants. When applied in urban farms, these next-generation sensing tools extract essential biochemical data directly from the plants and inform the farmer of early signs of plant stress in real time.


Fungal infections can be devastating to crops
Different kinds of stresses, such as bacterial and fungal infections, and heat and light stresses, induce distinct stress responses comprising dynamic changes in endogenous levels of various plant hormones and metabolites. The nanosensors enable real-time and reversible detection of these plant hormones and metabolites, capturing spatial and temporal changes that occur upon stress, way before physical symptoms are observable. This nanosensing platform is highly versatile and can be applied across various agriculturally relevant crop species.6
One such plant nanosensor that has recently been developed could selectively detect stress-induced hydrogen peroxide (H2O2) signalling waves in seven different plant species, including lettuce (Lactuca sativa), arugula (Eruca sativa), spinach (Spinacia oleracea), strawberry blite (Blitum capitatum), sorrel (Rumex acetosa) and thale cress (Arabidopsis thaliana).7
Depending on the type of stress inflicted on the plants, unique H2O2 signalling waveforms are generated, varying in amplitude, velocity and full-width-half-maximum. The H2O2 sensor can further be multiplexed with other plant hormone sensors for simultaneous detection, enabling a more accurate elucidation of particular stress types. Information from the nanosensors could also be captured remotely with portable electronics, allowing the farmer to adjust farming inputs, such as fertiliser, nutrients and pesticides, to mitigate the stress early and prevent potential crop losses.
These nanosensing toolsets have already significantly improved our understanding of plant physiological responses to external stresses at early stages before the onset of physical symptoms. Progress in this research area will hence be transformative in bridging the knowledge gap between model plants commonly used in plant biology laboratories, and economically important crops.
Development of portable Raman technology for detection of plant metabolites
Raman scattering is the inelastic scattering of light. Raman spectroscopy measures molecular vibrations, usually excited by a laser, in a sample, and the resulting Raman spectrum can act as a fingerprint for the material under investigation. This technique is non-invasive and provides information in real time. For example, by shining laser light on a leaf and measuring the scattered Raman light, one can predict the level of carotenoids, which are antioxidants, in the leaf. Similarly, Raman technology can be used for rapid diagnosis of plant stresses, such as nutrient deficiency and drought, before the onset of visible symptoms.
DiSTAP scientists have developed a portable Raman probe that clips onto a leaf for rapid, in vivo detection of plant metabolites, including carotenoids and nitrates. The leaf-clip Raman sensor has already been used for early diagnosis of nitrogen deficiency in the model plant Arabidopsis thaliana as well as commonly consumed vegetable crops in Singapore, Pak Choi (Brassica rapa chinensis) and Choy Sum (Brassica rapa var. parachinensis).8


Leaf-clip-enabled portable Raman system (developed in scientific collaboration with Technospex Pte Ltd) being used to measure plant metabolites
Using Raman spectral fingerprints, DiSTAP has developed a rapid method for the detection and quantification of early innate immunity responses generated by pathogen infection in Arabidopsis and Choy Sum (leafy vegetable) plants.
Plant diseases severely affect crop yields worldwide, and the use of non-destructive sensors to monitor plant health is a sustainable and attractive strategy for improving crop quality. Raman technology, as shown above, can aid in early detection of pathogen infection and greatly facilitate disease management.9 Moving forward, researchers seek to further advance these predictive and precise techniques to improve future farming practices and augment overall crop yield and productivity.
References
- Walia A, Waadt R, Jones A. 2018. Genetically encoded biosensors in plants: pathways to discovery.
- Lisec J, Schauer N, Kopka J, et al. 2006. Gas chromatography mass spectrometry–based metabolite profiling in plants. Nature protocols 1, 387-396.
- Ang MCY, Lew TTS. 2022. Non-destructive Technologies for Plant Health Diagnosis. Frontiers in Plant Science 13, 884454
- Kwak S-Y, et al. 2017. Nanosensor Technology Applied to Living Plant Systems. Annual Review of Analytical Chemistry 10, 113-140.
- Lew TTS, Koman VB, Gordiichuk P, et al. 2020. The Emergence of Plant Nanobionics and Living Plants as Technology. Advanced Materials Technologies 5, 1900657.
- Lew TTS, et al. 2020. Species-independent analytical tools for next-generation agriculture. Nature Plants 6, 1408-1417.
- Lew TTS, et al. 2020. Real-time detection of wound-induced H2O2 signalling waves in plants with optical nanosensors. Nature Plants 6, 404-415.
- Gupta S, Huang CH, Singh GP, et al. 2020. Portable Raman leaf-clip sensor for rapid detection of plant stress. Sci Rep 10, 20206. https://doi.org/10.1038/s41598-020-76485-5
- Chung PJ, Singh GP, Huang C-H, et al. 2021. Rapid Detection and Quantification of Plant Innate Immunity Response Using Raman Spectroscopy. Front. Plant Sci. 12:746586. doi: 10.3389/fpls.2021.746586
About the authors